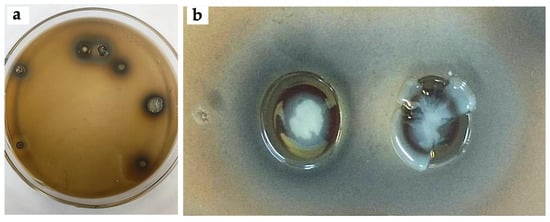
Evaluation of silver tolerance in bacterial strains isolated from mine tailings. (a) Minimum inhibitory concentration tests with AgNO3 (0.5 mM). (b) Phenotypes of bacterial colonies in response to the presence of AgNO3. The accumulation of soluble silver associated with bacterial exopolysaccharides is observed.

- Article
Lysinibacillus as Microbial Nanofactories: Genomic Mechanisms for Green Synthesis of Silver Nanoparticles (AgNPs)
- José Luis Aguirre-Noyola,
- Gustavo Cuaxinque-Flores and
- Jorge David Cadena-Zamudio
- + 3 authors
The green synthesis of silver nanoparticles (AgNPs) by bacteria is a strategic route for sustainable nanobiotechnology; however, the genomic and biochemical mechanisms that make it possible remain poorly defined. In this study, bacteria native to silver-bearing mine tailings in Taxco (Mexico) were isolated, capable of tolerating up to 5 mM of AgNO3 and producing extracellular AgNPs. Spectroscopic (430–450 nm) and structural (XRD, fcc cubic phase) characterization confirmed the formation of AgNPs with average sizes of 17–21 nm. FTIR evidence showed the participation of extracellular proteins and polysaccharides as reducing and stabilizing agents. Genomic analyses assigned the isolates as Lysinibacillus fusiformis 31HCl and L. xylanilyticus G1-3. Genome mining revealed extensive repertoires of genes involved in uptake, transport, efflux and detoxification of metals, including P-type ATPases, RND/ABC/CDF transporters, Fe/Ni/Zn uptake systems, and metal response regulators. Notably, homologues of the silP gene, which encode Ag+ translocator ATPases, were identified, suggesting convergent adaptation to silver-rich environments. Likewise, multiple nitroreductases (YodC, YdjA, YfKO) were detected, candidates for mediating electron transfer from NAD(P)H to Ag+. These findings support the role of Lysinibacillus as microbial nanofactories equipped with specialized molecular determinants for silver tolerance and AgNP assembly, providing a functional framework for microorganism-based nanobiotechnology applications.
19 December 2025